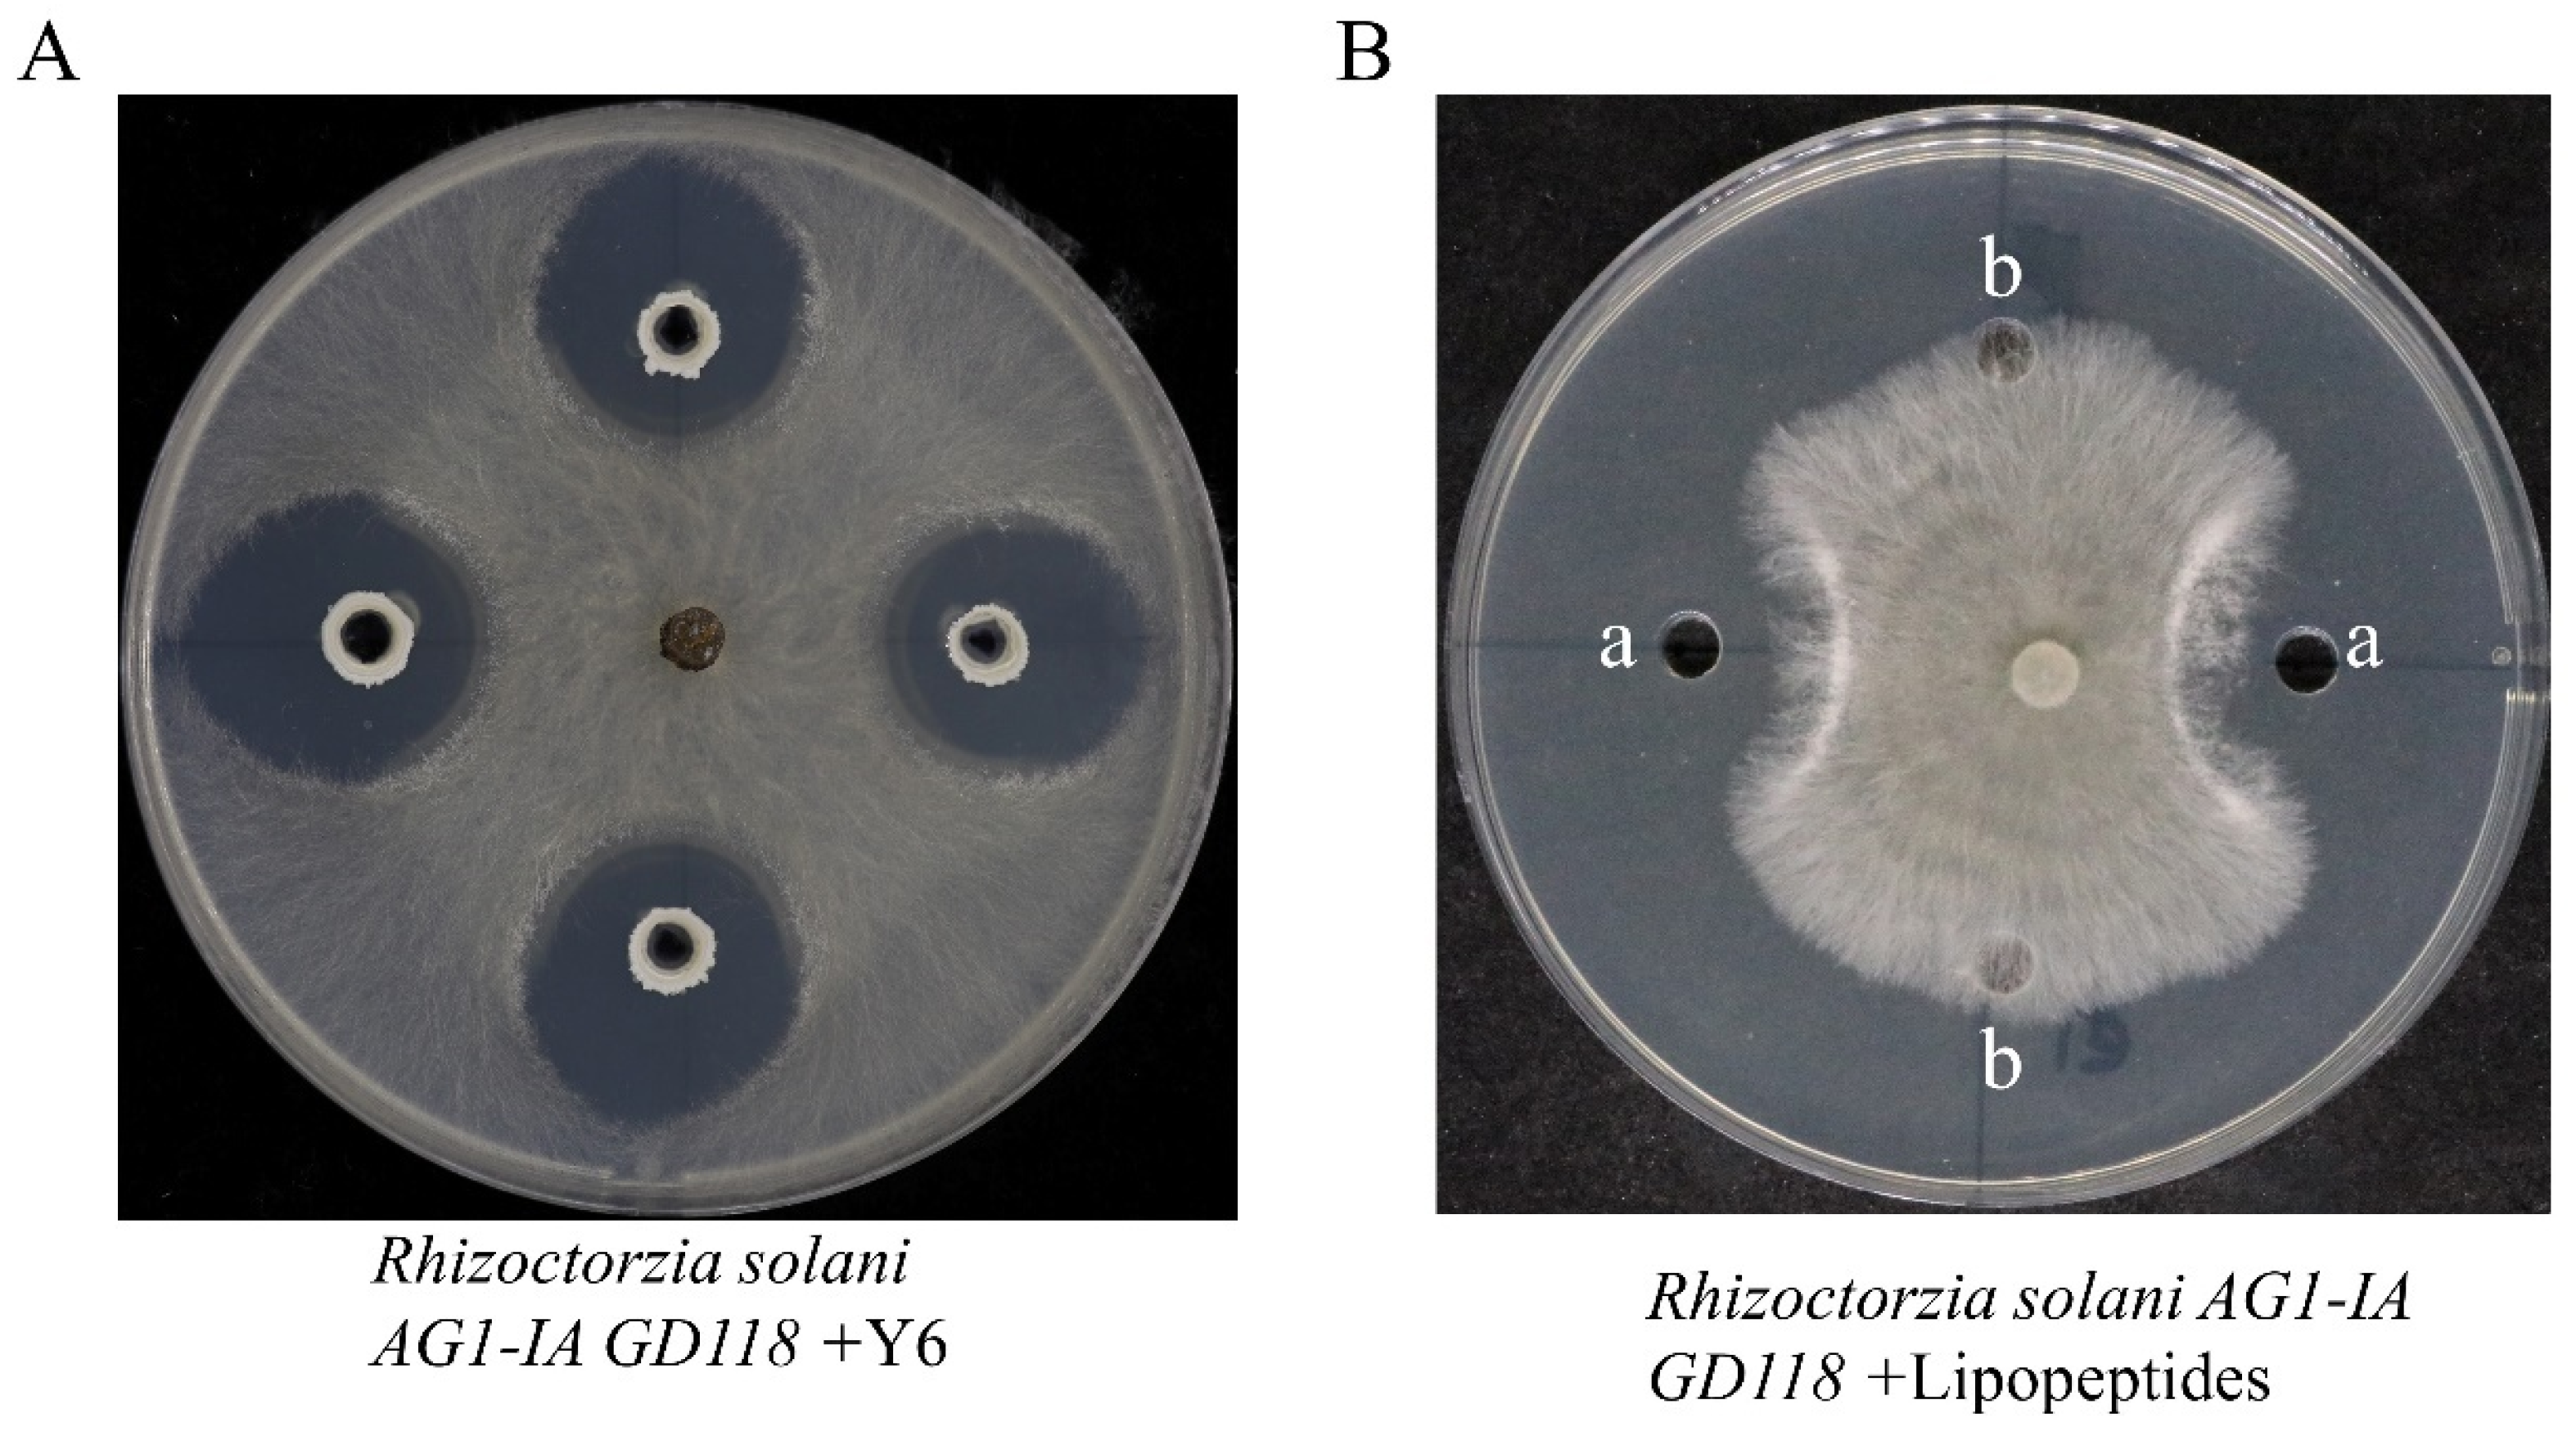

Bacillus velezensis Y6, a Potential and Efficient Biocontrol Agent in Control of Rice Sheath Blight Caused by Rhizoctonia solani
Abstract
1. Introduction
2. Materials and Methods
2.1. Strains and Growth Media
2.2. B. velezensis Y6 Antagonizes Rhizoctonia solani
2.3. Pot Experiment
2.4. Field Experiment
2.5. Extraction of Crude Lipopeptides
2.6. Extraction of Lipopeptides (LP) from the Transparent Inhibition Zone
2.7. Identification of LPs by UPLC/Q-TOF-MS
2.8. Total RNA Extraction and Transcriptomic Analysis
2.9. Statistical Analysis
3. Results
3.1. B. velezensis Y6 Can Effectively Inhibit the Growth of Rhizoctonia solani
3.2. Characterization of B. velezensis Y6-Secreted Lipopeptides by UPLC/Q-TOF-MS
3.3. Antibacterial Activity of B. velezensis Y6 and Its Derived Mutants against Rhizoctonia solani
3.4. Biocontrol Effects of Y6 on Rice Plant Tissues in Pot Experiment
3.5. B. velezensis Y6 Can Increase Rice Yield in the Field
3.6. Transcriptome Profiling Effects of Strain Y6 on Rice
4. Discussion
5. Conclusions
Supplementary Materials
Author Contributions
Funding
Data Availability Statement
Conflicts of Interest
References
- Bernardes-de-Assis, J.; Storari, M.; Zala, M.; Wang, W.; Jiang, D.; Shidong, L.; Jin, M.; McDonald, B.A.; Ceresini, P.C. Genetic structure of populations of the rice-infecting pathogen Rhizoctonia solani AG-1 IA from China. Phytopathology 2009, 99, 1090–1099. [Google Scholar] [CrossRef] [PubMed]
- Yu, Y.Y.; Jiang, C.H.; Wang, C.; Chen, L.J.; Li, H.Y.; Xu, Q.; Guo, J.H. An improved strategy for stable biocontrol agents selecting to control rice sheath blight caused by Rhizoctonia solani. Microbiol. Res. 2017, 203, 1–9. [Google Scholar] [CrossRef] [PubMed]
- Deng, S.; Guo, Q.; Gao, Y.; Li, J.; Xu, Z. Induced resistance to rice sheath blight (Rhizoctonia solani Kuhn) by beta-amino-butyric acid conjugate of phenazine-1-carboxylic acid. Pestic Biochem. Physiol. 2023, 194, 105502. [Google Scholar] [CrossRef] [PubMed]
- Park, D.S.; Sayler, R.J.; Hong, Y.G.; Nam, M.H.; Yang, Y. A Method for Inoculation and Evaluation of Rice Sheath Blight Disease. Plant Dis. 2008, 92, 25–29. [Google Scholar] [CrossRef] [PubMed]
- Senapati, M.; Tiwari, A.; Sharma, N.; Chandra, P.; Bashyal, B.M.; Ellur, R.K.; Bhowmick, P.K.; Bollinedi, H.; Vinod, K.K.; Singh, A.K.; et al. Rhizoctonia solani Kuhn Pathophysiology: Status and Prospects of Sheath Blight Disease Management in Rice. Front. Plant Sci. 2022, 13, 881116. [Google Scholar] [CrossRef] [PubMed]
- Akash Datta, A.D.; Vurukonda, S.S.K.P. Rice Sheath Blight: A Review of The Unsung Fatal Disease. Trends Biosci. 2017, 10, 9216–9219. [Google Scholar]
- Singh, R.; Singh, B.; Singh, A.; Kureel, R. Management of sheath blight in rice through application of Validamycin, Trichoderma harzianum and Pseudomonas fluorescence. J. Appl. Nat. Sci. 2010, 2, 121–125. [Google Scholar] [CrossRef]
- Meena, K.R.; Kanwar, S.S. Lipopeptides as the antifungal and antibacterial agents: Applications in food safety and therapeutics. Biomed Res. Int. 2015, 2015, 473050. [Google Scholar] [CrossRef] [PubMed]
- Veras, F.F.; Silveira, R.D.; Welke, J.E. Bacillus spp. as a strategy to control fungi and mycotoxins in food. Curr. Opin. Food Sci. 2023, 52, 101068. [Google Scholar] [CrossRef]
- Li, B.; Li, Q.; Xu, Z.; Zhang, N.; Shen, Q.; Zhang, R. Responses of beneficial Bacillus amyloliquefaciens SQR9 to different soilborne fungal pathogens through the alteration of antifungal compounds production. Front. Microbiol. 2014, 5, 636. [Google Scholar] [CrossRef]
- Etesami, H.; Jeong, B.R.; Glick, B.R. Biocontrol of plant diseases by Bacillus spp. Physiol. Mol. Plant Pathol. 2023, 126, 102048. [Google Scholar] [CrossRef]
- Yan, Y.; Xu, W.; Hu, Y.; Tian, R.; Wang, Z. Bacillus velezensis YYC promotes tomato growth and induces resistance against bacterial wilt. Biol. Control 2022, 172, 104977. [Google Scholar] [CrossRef]
- Zhang, S.; Wu, J.; Chen, J.; Jun, S.; Yuan, Y.; Dai, X.; Wang, F.; Ma, Y. The biological control effect of Bacillus cereus on strawberry leaf spot disease caused by Neopestalotiopsis clavispora. Sci. Hortic. 2024, 327, 112841. [Google Scholar] [CrossRef]
- Nie, P.; Li, X.; Wang, S.; Guo, J.; Zhao, H.; Niu, D. Induced Systemic Resistance against Botrytis cinerea by Bacillus cereus AR156 through a JA/ET- and NPR1-Dependent Signaling Pathway and Activates PAMP-Triggered Immunity in Arabidopsis. Front. Plant Sci. 2017, 8, 238. [Google Scholar] [CrossRef] [PubMed]
- Prasad, B.; Sharma, D.; Kumar, P.; Chandra Dubey, R. Biocontrol potential of Bacillus spp. for resilient and sustainable agricultural systems. Physiol. Mol. Plant Pathol. 2023, 128, 102173. [Google Scholar] [CrossRef]
- Han, V.-C.; Michael, P.J.; Swift, B.; Bennett, S.J. Biological control of Sclerotinia sclerotiorum: Modes of action of biocontrol agents, soil organic amendments, and soil microbiome manipulation. Biol. Control 2023, 186, 105346. [Google Scholar] [CrossRef]
- Feng, R.Y.; Chen, Y.H.; Lin, C.; Tsai, C.H.; Yang, Y.L.; Chen, Y.L. Surfactin secreted by Bacillus amyloliquefaciens Ba01 is required to combat Streptomyces scabies causing potato common scab. Front. Plant Sci. 2022, 13, 998707. [Google Scholar] [CrossRef] [PubMed]
- Wang, Y.; Liang, J.; Zhang, C.; Wang, L.; Gao, W.; Jiang, J. Bacillus megaterium WL-3 Lipopeptides Collaborate Against Phytophthora infestans to Control Potato Late Blight and Promote Potato Plant Growth. Front. Microbiol. 2020, 11, 1602. [Google Scholar] [CrossRef] [PubMed]
- Cao, Y.; Pi, H.; Chandrangsu, P.; Li, Y.; Wang, Y.; Zhou, H.; Xiong, H.; Helmann, J.D.; Cai, Y. Antagonism of Two Plant-Growth Promoting Bacillus velezensis Isolates Against Ralstonia solanacearum and Fusarium oxysporum. Sci. Rep. 2018, 8, 4360. [Google Scholar] [CrossRef] [PubMed]
- Tao, H.; Wang, S.; Li, X.; Li, X.; Cai, J.; Zhao, L.; Wang, J.; Zeng, J.; Qin, Y.; Xiong, X.; et al. Biological control of potato common scab and growth promotion of potato by Bacillus velezensis Y6. Front. Microbiol. 2023, 14, 1295107. [Google Scholar] [CrossRef]
- Zhao, H.; Shao, D.; Jiang, C.; Shi, J.; Li, Q.; Huang, Q.; Rajoka, M.S.R.; Yang, H.; Jin, M. Biological activity of lipopeptides from Bacillus. Appl. Microbiol. Biotechnol. 2017, 101, 5951–5960. [Google Scholar] [CrossRef] [PubMed]
- Ongena, M.; Jacques, P. Bacillus lipopeptides: Versatile weapons for plant disease biocontrol. Trends Microbiol. 2008, 16, 115–125. [Google Scholar] [CrossRef] [PubMed]
- Roongsawang, N.; Washio, K.; Morikawa, M. Diversity of nonribosomal peptide synthetases involved in the biosynthesis of lipopeptide biosurfactants. Int. J. Mol. Sci. 2010, 12, 141–172. [Google Scholar] [CrossRef] [PubMed]
- Sani, A.; Qin, W.Q.; Li, J.Y.; Liu, Y.F.; Zhou, L.; Yang, S.Z.; Mu, B.Z. Structural diversity and applications of lipopeptide biosurfactants as biocontrol agents against phytopathogens: A review. Microbiol. Res. 2024, 278, 127518. [Google Scholar] [CrossRef] [PubMed]
- Zhou, S.; Liu, G.; Zheng, R.; Sun, C.; Wu, S. Structural and Functional Insights into Iturin W, a Novel Lipopeptide Produced by the Deep-Sea Bacterium Bacillus sp. Strain wsm-1. Appl. Environ. Microbiol. 2020, 86, e01597-20. [Google Scholar] [CrossRef] [PubMed]
- Zeriouh, H.; de Vicente, A.; Perez-Garcia, A.; Romero, D. Surfactin triggers biofilm formation of Bacillus subtilis in melon phylloplane and contributes to the biocontrol activity. Environ. Microbiol. 2014, 16, 2196–2211. [Google Scholar] [CrossRef] [PubMed]
- Zhang, L.; Sun, C. Fengycins, Cyclic Lipopeptides from Marine Bacillus subtilis Strains, Kill the Plant-Pathogenic Fungus Magnaporthe grisea by Inducing Reactive Oxygen Species Production and Chromatin Condensation. Appl. Environ. Microbiol. 2018, 84, e00445-18. [Google Scholar] [CrossRef] [PubMed]
- Yang, H.; Li, X.; Li, X.; Yu, H.; Shen, Z. Identification of lipopeptide isoforms by MALDI-TOF-MS/MS based on the simultaneous purification of iturin, fengycin, and surfactin by RP-HPLC. Anal. Bioanal. Chem. 2015, 407, 2529–2542. [Google Scholar] [CrossRef]
- Zhang, R.-S.; Wang, F.-G.; Qi, Z.-Q.; Qiao, J.-Q.; Du, Y.; Yu, J.-J.; Yu, M.-N.; Liang, D.; Song, T.-Q.; Yan, P.-X.; et al. Iturins produced by Bacillus velezensis Jt84 play a key role in the biocontrol of rice blast disease. Biol. Control 2022, 174, 105001. [Google Scholar] [CrossRef]
- Hao, L.-y.; Liu, X.-y.; Zhang, X.-j.; Sun, B.-c.; Liu, C.; Zhang, D.-f.; Tang, H.-j.; Li, C.-h.; Li, Y.-x.; Shi, Y.-s.; et al. Genome-wide identification and comparative analysis of drought related genes in roots of two maize inbred lines with contrasting drought tolerance by RNA sequencing. J. Integr. Agric. 2020, 19, 449–464. [Google Scholar] [CrossRef]
- Bollier, N.; Micol-Ponce, R.; Dakdaki, A.; Maza, E.; Zouine, M.; Djari, A.; Bouzayen, M.; Chevalier, C.; Delmas, F.; Gonzalez, N.; et al. Various tomato cultivars display contrasting morphological and molecular responses to a chronic heat stress. Front. Plant Sci. 2023, 14, 1278608. [Google Scholar] [CrossRef] [PubMed]
- Liang, Y.; Tabien, R.E.; Tarpley, L.; Mohammed, A.R.; Septiningsih, E.M. Transcriptome profiling of two rice genotypes under mild field drought stress during grain-filling stage. AoB Plants 2021, 13, plab043. [Google Scholar] [CrossRef] [PubMed]
- Chaturvedi, A.K.; Bahuguna, R.N.; Shah, D.; Pal, M.; Jagadish, S.V.K. High temperature stress during flowering and grain filling offsets beneficial impact of elevated CO2 on assimilate partitioning and sink-strength in rice. Sci. Rep. 2017, 7, 8227. [Google Scholar] [CrossRef] [PubMed]
- Nahar, L.; Aycan, M.; Hanamata, S.; Baslam, M.; Mitsui, T. Impact of Single and Combined Salinity and High-Temperature Stresses on Agro-Physiological, Biochemical, and Transcriptional Responses in Rice and Stress-Release. Plants 2022, 11, 501. [Google Scholar] [CrossRef] [PubMed]
- Ngalimat, M.S.; Mohd Hata, E.; Zulperi, D.; Ismail, S.I.; Ismail, M.R.; Mohd Zainudin, N.A.I.; Saidi, N.B.; Yusof, M.T. Plant Growth-Promoting Bacteria as an Emerging Tool to Manage Bacterial Rice Pathogens. Microorganisms 2021, 9, 682. [Google Scholar] [CrossRef] [PubMed]
- Yadav, V.; Wang, Z.; Wei, C.; Amo, A.; Ahmed, B.; Yang, X.; Zhang, X. Phenylpropanoid Pathway Engineering: An Emerging Approach towards Plant Defense. Pathogens 2020, 9, 312. [Google Scholar] [CrossRef] [PubMed]
- Chen, O.; Deng, L.; Ruan, C.; Yi, L.; Zeng, K. Pichia galeiformis Induces Resistance in Postharvest Citrus by Activating the Phenylpropanoid Biosynthesis Pathway. J. Agric. Food Chem. 2021, 69, 2619–2631. [Google Scholar] [CrossRef] [PubMed]
- Vranic, M.; Perochon, A.; Doohan, F.M. Transcriptional Profiling Reveals the Wheat Defences against Fusarium Head Blight Disease Regulated by a NAC Transcription Factor. Plants 2023, 12, 2708. [Google Scholar] [CrossRef] [PubMed]
- Liu, H.; Wang, J.; Sun, H.; Han, X.; Peng, Y.; Liu, J.; Liu, K.; Ding, Y.; Wang, C.; Du, B. Transcriptome Profiles Reveal the Growth-Promoting Mechanisms of Paenibacillus polymyxa YC0136 on Tobacco (Nicotiana tabacum L.). Front. Microbiol. 2020, 11, 584174. [Google Scholar] [CrossRef] [PubMed]
- Noctor, G.; Cohen, M.; Trémulot, L.; Châtel-Innocenti, G.; Van Breusegem, F.; Mhamdi, A. Glutathione: A key modulator of plant defence and metabolism through multiple mechanisms. J. Exp. Bot. 2024, 75, 4549–4572. [Google Scholar] [CrossRef] [PubMed]

| Time (min) | Mobile Phase A% | Mobile Phase B% | Flow Rate |
|---|---|---|---|
| 4.5 | 80 | 20 | 0.3 mL/min |
| 5 | 80 | 20 | 0.3 mL/min |
| 7 | 95 | 5 | 0.3 mL/min |
| 9 | 95 | 5 | 0.3 mL/min |
| 10 | 40 | 60 | 0.3 mL/min |
| 15 | 40 | 60 | 0.3 mL/min |
| Strain | Diameter of the Inhibition Zone (mm) |
|---|---|
| WT (Y6) | 24.88 ± 0.22 a |
| 453 (srfAA::mls) | 24.50 ± 0.50 a |
| 454 (ituA::mls) | 17.13 ± 0.74 c |
| 459 (fenC::spc)) | 21.88 ± 0.65 b |
Disclaimer/Publisher’s Note: The statements, opinions and data contained in all publications are solely those of the individual author(s) and contributor(s) and not of MDPI and/or the editor(s). MDPI and/or the editor(s) disclaim responsibility for any injury to people or property resulting from any ideas, methods, instructions or products referred to in the content. |
© 2024 by the authors. Licensee MDPI, Basel, Switzerland. This article is an open access article distributed under the terms and conditions of the Creative Commons Attribution (CC BY) license (https://creativecommons.org/licenses/by/4.0/).
Share and Cite
Tao, H.; Li, X.; Huo, H.; Cai, Y.; Cai, A. Bacillus velezensis Y6, a Potential and Efficient Biocontrol Agent in Control of Rice Sheath Blight Caused by Rhizoctonia solani. Microorganisms 2024, 12, 1694. https://doi.org/10.3390/microorganisms12081694
Tao H, Li X, Huo H, Cai Y, Cai A. Bacillus velezensis Y6, a Potential and Efficient Biocontrol Agent in Control of Rice Sheath Blight Caused by Rhizoctonia solani. Microorganisms. 2024; 12(8):1694. https://doi.org/10.3390/microorganisms12081694
Chicago/Turabian StyleTao, Huan, Xiaoyu Li, Huazhen Huo, Yanfei Cai, and Aihua Cai. 2024. "Bacillus velezensis Y6, a Potential and Efficient Biocontrol Agent in Control of Rice Sheath Blight Caused by Rhizoctonia solani" Microorganisms 12, no. 8: 1694. https://doi.org/10.3390/microorganisms12081694
APA StyleTao, H., Li, X., Huo, H., Cai, Y., & Cai, A. (2024). Bacillus velezensis Y6, a Potential and Efficient Biocontrol Agent in Control of Rice Sheath Blight Caused by Rhizoctonia solani. Microorganisms, 12(8), 1694. https://doi.org/10.3390/microorganisms12081694

